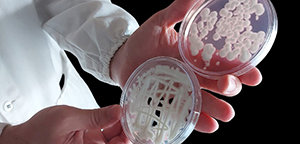

Lei dos Bioinsumos, crescimento acelerado do mercado e mudanças climáticas ampliam o debate sobre o papel estratégico dos agentes biológicos na proteção de plantas e na segurança alimentar
O aumento da temperatura, alterações nos regimes de chuva e maior concentração de CO₂ podem modificar o ciclo de vida de insetos pragas e de fitopatógenos, influenciar a suscetibilidade das plantas e alterar a distribuição geográfica de pragas e de doenças.
“O chamado triângulo da doença — hospedeiro suscetível, patógeno virulento e ambiente favorável — é profundamente afetado pelas mudanças climáticas”, explica Bettiol. “Se o ambiente muda, mudam também as relações entre planta, patógeno e os microrganismos, sejam os patogênicos ou os benéficos”.
Doenças causadas por vírus e molicutes e transmitidas por vetores, como pulgões, cigarrinhas, ácaros e mosca-branca, tendem a ganhar importância com o aumento da temperatura, já que esses vetores terão ciclos de vida mais curtos, maior atividade e maior longevidade. Consequentemente, levará a um aumento das populações e da aumento importância dessas doenças.
Além disso, as mudanças climáticas podem alterar a composição das comunidades microbianas da rizosfera (região das raízes), da filosfera (parte aérea) e do solo, impactando tanto o controle biológico natural quanto o conservacionista e o aumentativo.
“A eficácia dos agentes aplicados pode variar sob as novas condições ambientais. Por isso, é fundamental avaliar continuamente o desempenho desses organismos em cenários futuros”, afirma o pesquisador. Além disso, é importante selecionarmos os agentes de controle biológico pensando nos cenários futuros do nosso planeta. Essa seleção de agentes pensando nos cenários futuros já vem sendo realizada pela Embrapa Meio Ambiente em conjunto com a Embrapa Semiárido.
“A redução da soma de inóculo ou das atividades determinantes da doença, provocada por um patógeno, realizada por um ou mais organismos que não o homem, é o conceito mais aceito pela comunidade científica”, afirma o pesquisador Wagner Bettiol, da Embrapa Meio Ambiente. Na prática, isso significa interferir no crescimento, na infectividade, na virulência e na agressividade do patógeno, além de outros processos que determinam a infecção, o desenvolvimento de sintomas e a reprodução do agente causador da doença.
De acordo com o pesquisador, esse entendimento amplia significativamente o escopo do controle biológico. “Não se trata apenas de aplicar um microrganismo antagonista para controlar um determinado patógeno. Estamos falando de um conjunto de interações biológicas que podem envolver organismos avirulentos ou hipovirulentos da própria espécie patogênica, plantas com resistência estimulada, práticas culturais e microrganismos introduzidos ou de ocorrência natural que fortalecem a capacidade de resposta da planta”, explica.
Mercado adota visão mais restrita
Tanto o mercado brasileiro quanto o internacional adotam, em geral, um conceito mais simplificado de controle biológico de doenças de plantas, isto é, o uso de um antagonista para controlar um fitopatógeno. Para Bettiol, essa leitura é reducionista, mas facilita o entendimento dos atores envolvidos na cadeia produtiva.
“Quando o mercado restringe o controle biológico à aplicação de um produto comercial à base de um microrganismo antagonista, desconsidera outras estratégias igualmente importantes, como o manejo do ambiente para favorecer organismos benéficos ou o melhoramento de plantas para interagir melhor com esses bioagentes”, afirma.
Nos últimos anos, ganharam espaço os termos como biopesticidas, biofungicidas e bioprotetores. Biopesticidas incluem organismos vivos — fungos, bactérias, vírus e oomicetos — além de nematoides, predadores, parasitoides e produtos naturais derivados desses organismos, usados na proteção das plantas.
No entanto, Bettiol pondera que nem todos os mecanismos de controle envolvem a morte do patógeno. “Muitos agentes não eliminam, não matam o fitopatógeno, mas protegem a planta por outros mecanismos. Por isso, o termo ‘bioprotetores’ é o mais adequado em vários casos”, destaca.
Quatro tipos de controle biológico
O controle biológico pode ser dividido de uma forma didática em quatro modalidades: natural, conservacionista, clássico e aumentativo. No controle biológico natural, pragas e doenças são mantidas em equilíbrio por ação de inimigos naturais e de antagonistas sem intervenção humana — um serviço ecossistêmico essencial. No conservacionista, práticas agrícolas são adotadas para preservar e estimular esses organismos benéficos de ocorrência natural.
Já o controle biológico clássico envolve a introdução de inimigos naturais de uma região de origem da praga para outra onde se deseja controlar o problema fitossanitário. O controle biológico aumentativo, o mais conhecido pelos agricultores, baseia-se na aplicação massal e periódica de agentes de biocontrole disponíveis comercialmente. Para tanto, há necessidade de realizar a produção industrial destes organismos e registrar para disponibilizar aos agricultores.
“Cada estratégia tem seu papel dentro de um programa de manejo. O desafio é integrar essas abordagens”, ressalta Bettiol.
Programa Bioinsumos e nova lei impulsionam setor
Para estimular o uso de produtos biológicos na agricultura, o Governo Federal instituiu, em 2020, o Programa Nacional de Bioinsumos. A política ganhou reforço com a aprovação da Lei nº 15.070, em dezembro de 2024, que definiu oficialmente o conceito de bioinsumo e estabeleceu diretrizes para produção, comercialização e uso.
A nova legislação considera bioinsumo, de uma forma simplificada, como sendo produtos, processos ou tecnologias baseados em agentes biológicos – de origem vegetal, animal ou microbiana – utilizados na agricultura, florestas plantadas e pecuária para nutrir o solo, estimular o crescimento de plantas e controlar pragas/doenças. “É importante entender que o incentivo não é apenas ao controle biológico, mas a um conjunto mais amplo de soluções biológicas para a agricultura”, observa Bettiol.
O mercado brasileiro de controle biológico vem crescendo de forma consistente. Dados do setor indicam que a área potencial tratada com agentes de biocontrole saltou de cerca de 47 milhões de hectares na safra 2022/2023 para quase 79 milhões de hectares na safra 2024/2025, com crescimento superior a 34% no último ciclo analisado.
Bionematicidas e bioinseticidas lideram o uso, representando 78% da área potencial tratada na safra 2024/2025. Biofungicidas responderam por 21%. Ainda assim, os produtos biológicos representam cerca de 7% do mercado total de produtos destinados à proteção vegetal no país, excluídos os herbicidas — segmento no qual ainda não há bioherbicidas comercializados. Esses números colocam o Brasil entre os maiores produtores e consumidores globais de agentes de biocontrole, afirma Bettiol.
Mudanças climáticas ampliam desafios
O avanço do controle biológico ocorre em um contexto de crescente preocupação com as mudanças climáticas. Segundo o relatório mais recente do Painel Intergovernamental sobre Mudanças Climáticas – IPCC -, divulgado em 2023, o aquecimento global deve continuar aumentando nas próximas décadas, com impactos diretos sobre a agricultura.
Papel estratégico na segurança alimentar
A ocorrência de doenças, pragas e plantas daninhas é um dos principais fatores de risco à segurança alimentar global. Nesse cenário, o controle biológico ganha importância não apenas como alternativa aos produtos químicos, mas como componente essencial de sistemas agrícolas mais resilientes e mais sustentáveis.
Para Bettiol, o fortalecimento da base científica, a adaptação das estratégias de manejo e o desenvolvimento de novas cultivares resistentes serão decisivos. “É certo que a importância do controle biológico tende a aumentar. A sociedade reconhece que a sustentabilidade dos agroecossistemas depende, cada vez mais, do uso inteligente dos processos biológicos”, conclui.
Com mercado em expansão, respaldo legal recente e pressão por sistemas produtivos menos impactantes, o controle biológico deixa de ser alternativa e passa a ocupar posição central nas estratégias de proteção de plantas no Brasil e no mundo.
Este estudo faz parte de capítulo do livro Biocontrole em patologia de plantas: conceitos e inovações, organizado pelo Grupo de Investigações em Fitopatologia, da Universidade Federal de Santa Maria.
Cristina Tordin (MTB 28499/SP)
Embrapa Meio Ambiente